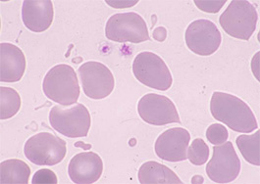

Q1. 下図から赤血球形態の組み合わせで正しいものはどれですか。
 |
 |
|---|---|
|
|
赤血球の膜に穴があく外因性欠陥によって膜統合性の破綻が起こり溶血性貧血、血管内溶血を引き起こします。 |
赤血球には耐え得る限界以上の外力が加わると赤血球膜は伸展せずに引き裂かれる習性があります。 |
HOME > 血液検査コーナー > 「ネットで形態」 血液形態自習塾 > 第2部 > 2.実践的な観察・末梢血編
「ネットで形態」 血液形態自習塾 第2部
末梢血・骨髄像の見方&考え方
|
 |
|---|---|
|
|
赤血球の膜に穴があく外因性欠陥によって膜統合性の破綻が起こり溶血性貧血、血管内溶血を引き起こします。 |
赤血球には耐え得る限界以上の外力が加わると赤血球膜は伸展せずに引き裂かれる習性があります。 |